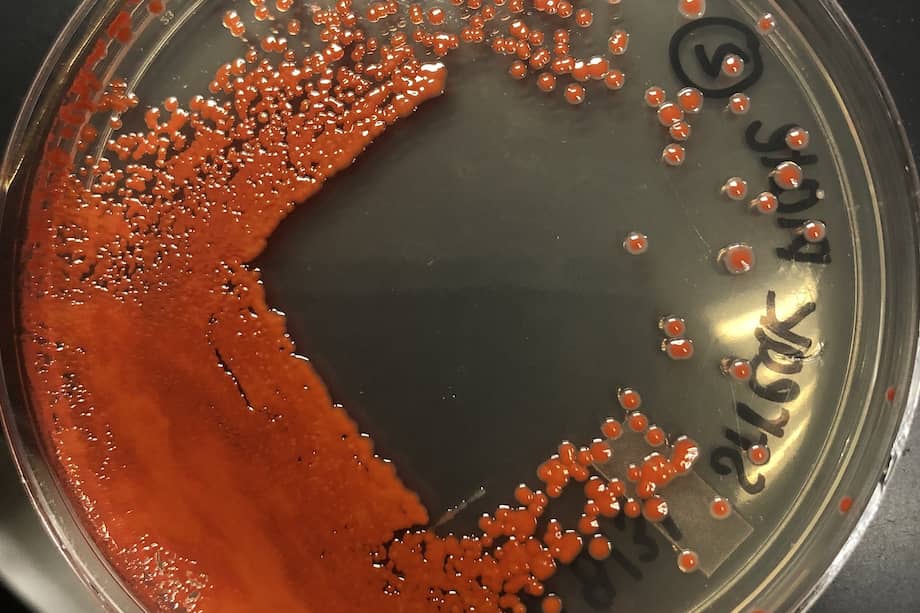
Imagen de la bacteria "Serratia marcescens" en una caja de petri.

Escucha este artículo
Audio generado con IA de Google
0:00
/
0:00
Durante siglos, las lágrimas rojas en imágenes religiosas fueron interpretadas como milagros. Una figura sagrada que “llora sangre” parece, inevitablemente, querer decirnos algo. Y ante lo que no entendemos, los humanos tendemos a construir un significado sobrenatural.
Hoy, sin embargo, sabemos que en muchos de estos casos la explicación es sencilla, pero no por ello menos interesante. La bacteria Serratia marcescens produce un pigmento rojo intenso, la prodigiosina, capaz de generar manchas que evocan esas lágrimas. Este microorganismo habita en múltiples entornos, especialmente donde hay humedad, materia orgánica disponible y niveles reducidos de oxígeno.
(Lea Esta es la primera foto de la Tierra tomada desde la cara oculta de la Luna)
Entonces, ¿por qué aparece “justo ahí”? ¿Por qué en una estatua religiosa y no en cualquier otro lugar?
La respuesta no es mística, sino biológica. Las superficies donde se reportan estos fenómenos suelen presentar pequeñas irregularidades, grietas, poros o relieves, que facilitan la acumulación de polvo y materia orgánica. Estos microambientes retienen humedad y reducen la concentración de oxígeno, favoreciendo el crecimiento de bacterias anaeróbicas o facultativas como Serratia. No es que la bacteria “escoja” una estatua, simplemente encuentra ahí condiciones propicias para crecer.
Este fenómeno no es exclusivo de contextos religiosos. En cuerpos de agua, por ejemplo, es común observar manchas de colores intensos, verdes, amarillas, rosadas o rojas, producto del crecimiento de microorganismos pigmentados. En esos casos, la explicación biológica se acepta sin resistencia; nadie interpreta una laguna rojiza como un mensaje divino.
La diferencia no está en el fenómeno, sino en nuestra percepción. Si esa misma mancha apareciera en una alcantarilla, una pared húmeda o una cañería, sería vista como suciedad. Pero cuando ocurre sobre un símbolo cargado de significado, como una virgen o un santo, la interpretación cambia. Aquí lo que ocurre es un fenómeno psicológico conocido como sesgo de interés.
Prestamos atención selectiva a aquello que nos resulta significativo. Filtramos el mundo no solo por lo que ocurre, sino por dónde ocurre. Así, entre miles de eventos cotidianos invisibles, uno adquiere relevancia por su contexto. No porque sea único, sino porque nos interpela.
A esto se suma nuestra tendencia a buscar patrones y construir narrativas. Somos expertos en conectar puntos, incluso cuando no forman una figura real. Es el mismo mecanismo que lleva a algunos a ver predicciones en caricaturas como Los Simpson o a encontrar sentido en coincidencias improbables. No es que el fenómeno sea extraordinario, sino que nuestra interpretación lo convierte en tal.
Quizás el verdadero milagro no sea que una estatua llore rojo, sino que la vida, en sus formas más simples, sea capaz de generar procesos químicos complejos, elegantes, sorprendentes, que nos conmueven y nos inquietan.
*David A. Montero es Doctor en Ciencias Biomédicas y profesor de la Universidad de Chile.
👩🔬📄 ¿Quieres conocer las últimas noticias sobre ciencia? Te invitamos a verlas en El Espectador. 🧪🧬
